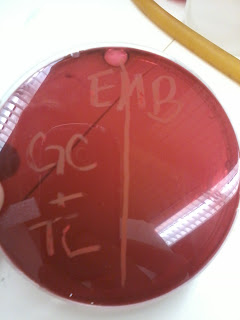

This test determines the ability of a bacterium to hydrolyze urea with an enzyme called urease; urea is a small molecule excreted in urine to elimniate nitrogenous waste from the body. This plate contains a pH indicator also called phenol red, because urease breaks urea down into carbon dioxide and ammonia which makes the pH more alkaline. So, a positive test makes the test tube a pink color, while a yellow color indicates no reaction (a negative result).
![]() |
| Urea test: before incubation. |
Differential Plates
a) MacConkey
This selective and differential media, differentiates among gram-negative enteric bacilli, based on their ability to grow on the medium and ferment lactose; these agar plates are often used in to process fecal matter specimens. Gram positive bacteria are inhibited on this growth plate, because crystal violet and bile salts are included in the medium. Lactose-fermenting colonies produce acids and have a pink to red color becuase of the pH indicator; non-lactose-fermenting colonies are colorless.
![]() |
| McConkey agar before incubation: Our test on left side. |
b) EMB - Eosin Methylene Blue Plate
This test isolates and differentiates gram-negative enteric bacilli. It contains eosin dye, methylene dye, lactose, and sucrose. It is a differential media that shows what bacteria ferment lactose and/or sucrose, and those that do not. If a bacteria does ferment these sugars, the dyes will precipitate on the colonies becuase of lower pH; slight carbohydrate fermentation causes a purple/pinkish sheen to the bacterial colonies and no fermentation causes no change in colony formation or color of the agar.
![]() |
| EMB before incubation: Our test on left side. |
c) Mannitol Salt
Manitol salt agar is meant to be a selective media to islate bacteria based ont heir salt tolerance and differentaite among these isolates for mannitol fermentation. Acid prodcued from the fermentation will cause the pH indicator, phenol red, to change to a yellow colored zone around the bacterial colonies (positive test); a negative test results in no change of color around bacterial colonies.
d) Blood Agar
This plate is an enriched medium with 5% red blood cells, to isolate and grow fastidious bacteria in clinical specimens. This differential media separates bacteria according to their ability to lyse blood cells- alpha, beta, or gama hemolysis. Alpha hemolysis gives off a green sheen to the agar plate, while in beta hemolysis, clear areas can be seen around bacterial colonies. Gama hemolysis shows no change in the blood agar plate.
Phenylethyl Alcohol Agar
This growth plate isolates gram-positive bacteria from a specimen containg a mixture of gram-positive and gram-negative bacteria. It is a selective media, becuase PEA inhibits or slows the growth of gram-negative gacteria by interfering with DNA synthesis.
![]() |
| PEA agar before incubation: Our test on left. |
Nitrate Reduction Test
The nitrate test determines if a bacterium is able to reduce nitrate ions ot either nigrate ions or nitrogen gas. When the enzyme nitrate reductase is present, it facilitates the recution of the nitrate ion to nitrite ions and water. Anaerobic bacteria are able to reduce nitrate completely to molecular nitrogen in a process called denitrification. After inoculation and incubation, reagents sulfanilic acid and dimethyl-a-naphthylamine are added and if nitrite is present (a positive test) the solution will turn pink; if not, the solution will stay a yellowish color. The addition of zinc powder may be added becuase it will reduce nitrate ions to nitrite ions- this would be a false positive test.
![]() |
| Nitrate test before incubation. |
Oxidase Test
This test determines if bacteria have cytochrome oxidase, a necessary enzyme in the electron transport chain during respiration. We did not follow this procedure completely in that we did not culture a plate, but we used an already cultured plate to test. In this test a reagent N,N,N,N, tetramethy-p-phenylenediamine is added. If the color of the bacteria immediately turned purple, the test was positve for cytorchrome oxidase, if not the color stayed the same (negative test).
Since we already has a cultured plate, we added the reagent and at first it was difficult to tell if our bacteria would change color (especially since it was already a deep red color). After comparing it to others' tests, our oxidase test came out negative and did not turn purple.
![]() |
| Oxidase test: Top. |
Making Yogurt
To make yogurt you heat up milk (preferably whole milk) by heating it until it boils and puffs up with bubbles; you do this to sterilize the milk, and give the bacteria you add to it, a broth to grow in. You then and cool it down to 37 degree centigrad (which makes the best yogurt) and add the active yogurt cultures and put it into 37 incubator (this can also be done in an oven overnight, with just the oven light on). To cool faster, transfer the milk from one cup to another cups, allowing the milk to airate. At home, if you touch the mug, it should be almost your temperature. We sprayed all utensiles with alcohol to keep them sterile, and from contaminating the milk with other unwanted bacteria. We made two different kinds of yogurt; one with the kroger active cultures and one with Dr. Joseph's cultures, originally from India. For them to be good active cultures, they should form yogurt within 6-24 hours.
We then finished our last movie, Outbreak. :)

No comments:
Post a Comment